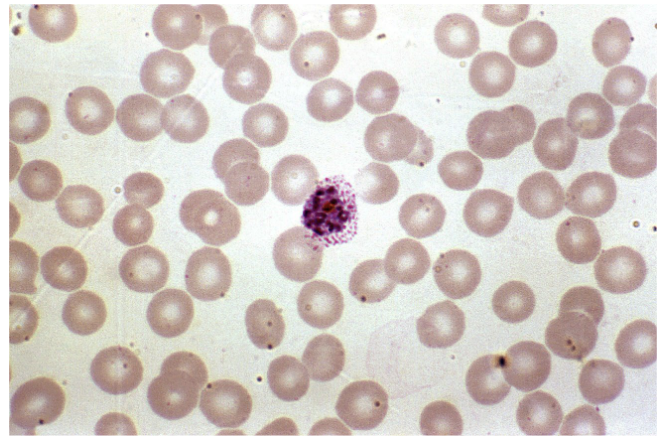
term image
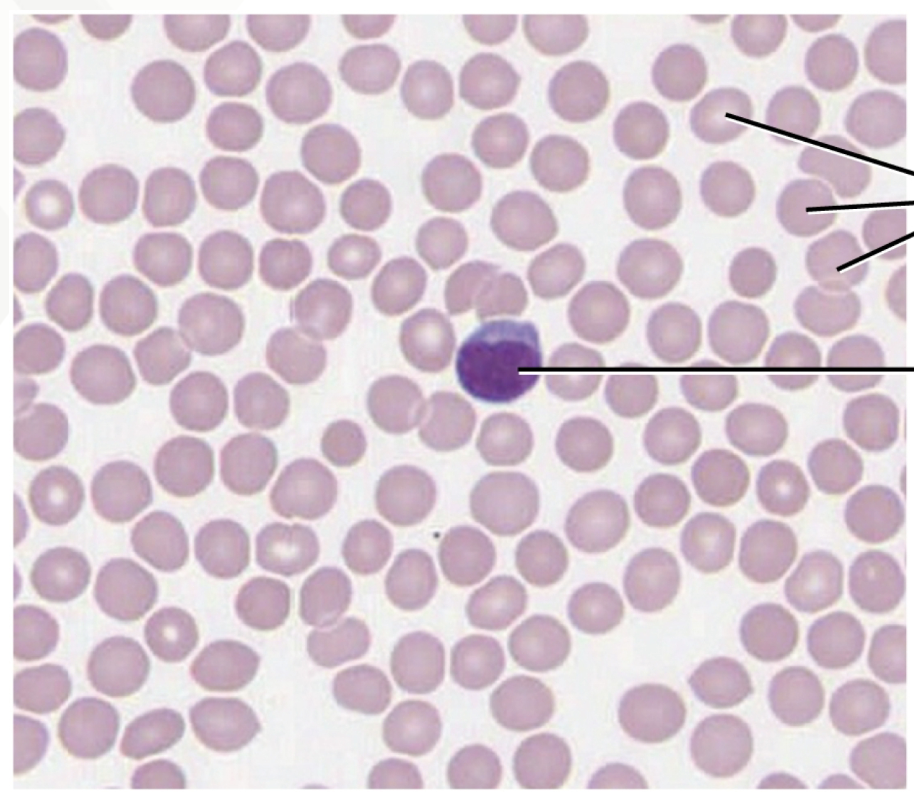
<p>Blood Connective Tissue</p><p>red blood cells - erythrocytes (pink)</p><p>white blood cells - leukocytes (purple)</p><p>platelets - thrombocytes </p><p>plasma - extracellular matrix </p>

A&P lab exam 2
1/36
Earn XP
Description and Tags
Histology and Cell Physiology
Name | Mastery | Learn | Test | Matching | Spaced | Call with Kai |
|---|
No analytics yet
Send a link to your students to track their progress
37 Terms
What is Diffusion?
The movement of a solute from a region of high concentration to low concentration. (Passive transport)
How does temperature affect the rate of diffusion?
As temp increases the molecules move faster.
Hotter=Faster
How does Viscosity (thickness) affect the rate of diffusion?
As viscosity increases diffusion will decrease.
Thicker/ more Viscosity=Slower
How does molecular size affect the rate of diffusion?
The larger the molecule the harder it is to diffuse.
Bigger=Slower
How does molecular weight affect the rate of diffusion?
The weight and diffusion is inversely proportional
Heavier = Slower
What is osmosis?
The movement of WATER through a semipermiable membrane from high to low concentration
What happens to a cell in a hypotonic solution?
solution that has lower solute outside the cell rather than inside, water moves INTO the cell —> Cell Swells or bursts (Lysis)
What happens to a cell in a hypertonic solution?
solution that has a higher concentration of solutes outside the cell rather than inside, water moves OUT of the cell —> cell shrivels or shrinks (crenates)
What happens to a cell in an isotonic solution?
both solutions contain the same amount of solute molecules. net movement of water is 0 —> cell maintains normal shape and size
What is filtration?
a solvent and its dissolved substances will move from high pressure to low pressure.
The effect of Viscosity on diffusion rate experiment
The viscosity of the agar is higher than water so diffusion happens faster in water.
The effect of Molecular size/weight on diffusion rate expirament
the higher the weight/size the slower the diffusion, potassium permanganate diffused faster than methylene blue because potassium is smaller and lighter.
The effect of Particle size on diffusion rate
The bigger the particle the slower/ less likely to diffuse. The smaller the particle the faster/easier to diffuse. starch didn’t diffuse bc larger, salt/NaCl did diffuse bc smaller, egg didn’t diffuse bc bigger, glucose did diffuse bc smaller.
Osmosis reaction
THe egg in water gained weight because water was moving into the egg, it was a hypotonic solution. the egg in Karo syrup lost weight because it was a hypertonic solution, water was moving out of the egg.
Cell Tonicity Reaction
0.9% NaCl is isotonic. below that (ex. 0.1%/0.5% NaCl) are hypotonic solutions, the cell will expand/lysis. above (ex. 2%/5% NaCl) are hypertonic solutions, the cell will shrink/crenate.
Epithelial Tissue
continuous sheets in single or multiple layers, connected to basement membrane , closely packed with little intercellular space between plasma membranes
Avascular
High rate of cell division (mitosis occurs often)
extensive intervention
FUNCTIONS; selective barrier, secretory surface, protective surface, sensations(nerve endings)

Simple Squamous Epithelial
Function: Filtration, Secretion, Diffusion, Osmosis
Found in: lines heart, blood, lymphatic vessels, and alveoli of lungs


Stratified Squamous Epithelial
Function: Protection
Found in: epidermis of skin, lines oral cavity, esophagus and vagina


Pseudostratified Ciliated Columnar Epithelial
Function: protection and secretion / movement of mucus
Found in: lines airways of respiratory tract, lines glands and ducts


Simple Columnar Epithelial
Function: (ciliated) - moves substances/ mucus by ciliary action
(non-ciliated) - Secretion and absorption
Found in: (ciliated) - lines bronchioles of respiratory tract, uterine tubes, and uterus
(non-ciliated) - lines GI tract, ducts, glands, and gallbladder

Connective Tissue
Binds, Supports, protects - most diverse tissue
HIGHLY VASCULAR

Areolar Connective
most widely distributed
Function: Protects and Binds
Found in: Subcutaneous layer of deep skin, surrounds nerves and organs, makes up dermis of the skin


Adipose Connective
made of adipocytes that store triglycerides
Function: supports and protects various organs; good insulator; reserve for energy
Found in: subcutaneous layer deep to the skin and surrounds organs


Dense Regular Connective
collagen fibers in bundles with fibroblasts in rows between bundles
Function: provides strong attachment between structures
Found in: forms tendons, ligaments, and aponeuroses

Blood Connective Tissue
red blood cells - erythrocytes (pink)
white blood cells - leukocytes (purple)
platelets - thrombocytes
plasma - extracellular matrix

Bone Connective Tissue:
Compact Bone front
Spongey Bone back


Skeletal Muscle
Striated, Multinucleated, and Voluntary
attached to bones by tendons


Cardiac Muscle
Striated, Single Nucleus, and Involuntary
Found in: walls of heart ONLY
have intercalated discs : attach cells together


Smooth Muscle
Non-striated, Single nucleus, and Involuntary
Found in: Many organs/structures like blood vessels, airways to lungs, stomach, intestines, gallbladder, etc..


Nervous/ Neuron
Cell body/Soma : one nucleus and various organelles
Dendrites: Short extensions of cell body that receive electrical impulses
Axon: Large single extension of cell body that transmit electrical impulses Away from cell body

What is the function of Adipocytes?
They store triglycerides
What tissues are Avascular?
Epithelial and Cartilage tissues
What are the 3 types of Cartilage?
Fibrocartilage: intervertebral discs, menisci of knee, pubic symphysis
Hyaline Cartilage: end of long bones, nose larynx, and bronchi
Elastic Cartilage: top of larynx, external ear, and auditory tubes
What are the types of Loose Connective Tissue?
Areolar
Reticular
Adipose
What are the types of Fluid Connective Tissue?
Blood
Lymph
What is the purpose of the Dendrites in a neuron?
receive electrical impulses
What is the purpose of the axon in a neuron?
send out electrical impulses